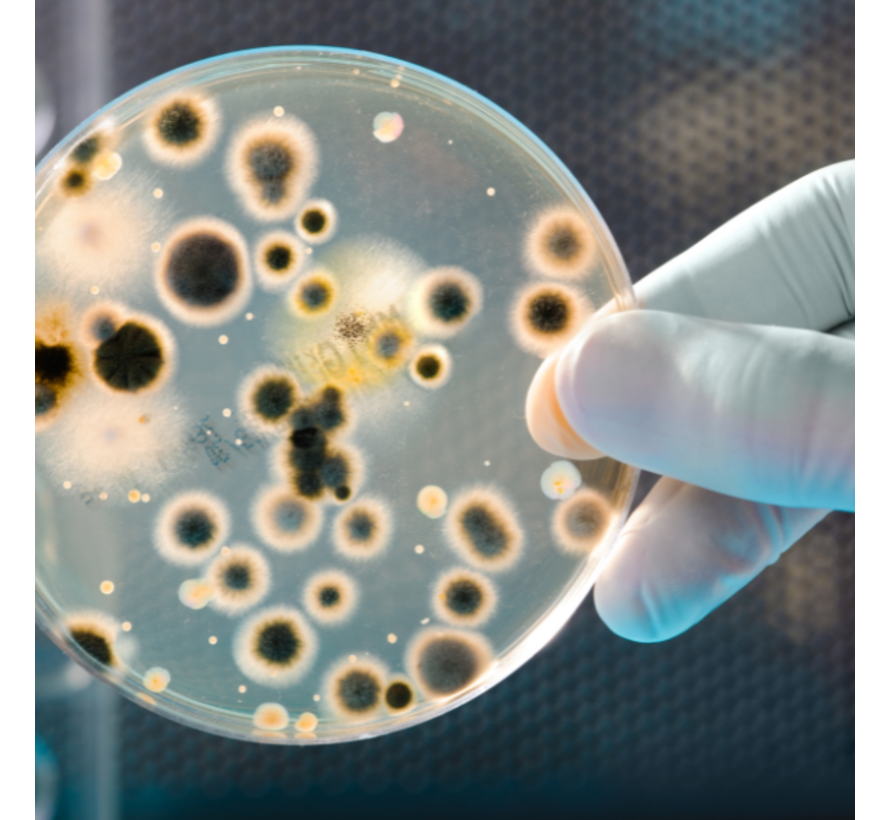

Algemene Kweek Bacteriën in ontlasting
Algemene kweek om bacteriën in ontlasting te onderzoeken.
Afdeling: BACTERIOLOGIE
De volgende bacteriën worden onderzocht:
- Salmonella kweek
- Shigella kweek
- Yersiniae kweek
- Campylobacter jejuni/coli
De kosten bedragen €25,-. Echter, als er iets gevonden wordt, vindt automatisch verder onderzoek plaats, waarmee de kosten kunnen oplopen.
Als je deze test bestelt ga je automatisch akkoord met de eventuele meerkosten van het vervolg onderzoek. Noteer in je winkelmandje bij het opmerkingenveld: Ik ga akkoord met eventuele extra kosten voor het vervolgonderzoek.
Het onderzoek kan niet tussentijds stopgezet worden.